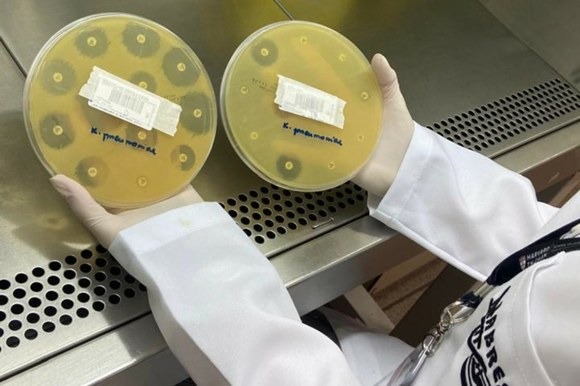
Na foto, comparativo de antibióticos fazendo efeito sobre a bactéria e aquele em que a bactéria é resistente ao tratamento.

Pesquisa revela alta de infecções sanguíneas em hospitais brasileiros por bactérias resistentes
Uma pesquisa liderada pelo professor do Departamento de Medicina Interna da UFRGS Alexandre Zavascki avaliou a ocorrência de bactérias que causam infecções na corrente sanguínea de pacientes em 14 hospitais envolvendo quatro das cinco regiões brasileiras. Foram analisadas as bactérias Enterobacterales, Acinetobacter baumannii, Pseudomonas aeruginosa, Staphylococcus aureus e Enterococcus faecium, consideradas pela Organização Mundial da Saúde (OMS) como as mais resistentes à ação de antimicrobianos (antibióticos).
Esse estudo é inédito em países de baixa e média renda, porque coleta pela primeira vez amostras de sangue prospectivamente de pacientes internados em hospitais brasileiros. Segundo Zavascki, dados sobre bactérias do Fenótipo de Resistência Antimicrobiana Prioritária da OMS (WPAP, abreviatura em inglês) de países de baixa e média renda são escassos. “Neste estudo, investigamos a ocorrência de WPAP em infecções da corrente sanguínea (BSI) associadas à assistência à saúde no Brasil. Diferente do Norte, nações do Sul Global têm acesso limitado a antibióticos e serviços de saúde, apresentando as maiores taxas de mortalidade por idade à resistência antimicrobiana (RAM)”, explica ele.
O artigo “Resistência antimicrobiana prioritária da Organização Mundial da Saúde em infecções da corrente sanguínea associadas à assistência à saúde por Enterobacterales, Acinetobacter baumannii, Pseudomonas aeruginosa, Staphylococcus aureus e Enterococcus faecium no Brasil (ASCENSION): um estudo prospectivo, multicêntrico e observacional” (tradução livre) foi publicado online na última semana na conceituada revista internacional The Lancet Regional Health – Americas.
Foi feita a análise de sangue de 1.114 pacientes que tiveram infecção da corrente sanguínea, resultando em uma amostra de 1.350 bactérias de interesse a serem estudadas. Os dados revelaram uma alta frequência de bactérias com fenótipo de resistência (que causam infecções de resistência crítica ou alta), sendo que 38,8% das bactérias isoladas eram do tipo crítica ou altamente resistente ao tratamento com antibióticos. Na Unidade de Tratamento Intensivo (UTI), o cenário foi ainda mais preocupante, com bactérias resistentes foco do estudo respondendo por 50% de todos os isolados.
“O nosso resultado mostra a realidade do que está acontecendo em hospitais brasileiros, revelando uma alta frequência de infecções por bactérias altamente resistentes aos antibióticos a que temos acesso no Brasil. Essas infecções associadas à assistência à saúde por bactérias altamente resistentes se tornam um grande problema de saúde pública no país”, explica Zavascki.
As bactérias estudadas pelos pesquisadores são consideradas umas das mais graves e as que mais causam morte e impacto clínico. Elas circulam nos hospitais e acabam sendo transmitidas de paciente para paciente dentro desses ambientes. A pesquisa mostra que em 28 dias a mortalidade de pacientes infectados por essas bactérias resistentes foi, aproximadamente, 36% maior do que daqueles que tiveram infecções por bactérias sensíveis a antibióticos prioritários.
“As infecções graves por bactérias são frequentes e difíceis de tratar. Por isso, essa investigação alerta para a necessidade da implantação efetiva de planos nacionais em hospitais brasileiros a partir de orientações da OMS, com ações que reduzam o risco de infecções e a transmissão dessas bactérias resistentes nesses locais, além de ampliação do acesso a novos antimicrobianos”, pontua o pesquisador da UFRGS.
Os dados da pesquisa foram coletados entre 15 de agosto de 2022 e 14 de agosto de 2023 em 14 hospitais brasileiros. Agora os pesquisadores seguem com a análise dos dados coletados para verificar como as bactérias se comportam com antibióticos comercializados no Brasil como também com aqueles em uso e acesso somente a pacientes do Norte Global.